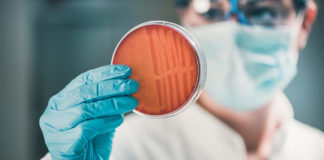
Antibiotics: Blind optimism is dangerous

The applications and pitfalls of critical thinking
				                                    					Critical thinking is not a cure-all, but it proves very useful in dealing with, clarifying, and solving some decision-making problems, as well as the thought and belief disputes which occupy our minds.				            
            
        How to make sure we have a rational faith
				                                    					Fundamentalist movements, extremist and sectarian religious beliefs, manipulations of the mass of believers, conspiracy theories within religious sects, and other such threats, emphasise the need for critical thinking.				            
            
        How to build valid arguments
				                                    					Arguments must be convincing and, in order to convince, they must be valid—the minimum requirement of persuasion.				            
            
        Reacting to the worst news
				                                    					In a conversation with Dr. Shelly-Ann Bowen, we discussed her research on what determines whether someone will be active or passive in the face of catastrophic events—fires, floods, or a cancer diagnosis. Social injustice, a lack of self-awareness, and even an immature understanding of faith paralyse action. But there are ways to make positive changes.				            
            
        Never enough: an imperfect article on perfectionism
				                                    					The end of the line for Christian perfectionism is not perfection, but atheism. This is because what we imagine to be the constant unsatisfied look of God upon us, is a burden too heavy for any human to bear.				            
            
        The need for certainty
				                                    					As we look at ourselves from the outside, taking our life seriously becomes difficult. This loss of confidence, as well as the attempt to regain it, are both matters related to the meaning of life. – Thomas Nagel, View from Nowhere				            
            
        How to develop your creativity every day
				                                    					Even if half of us refer to creativity as a rare trait that only the other half has, in reality, creativity is much like a muscle: the more we use it, the more creative we become.				            
            
        What we can learn from children facing death
				                                    					For many years, Dr Jonathan Ward was a military chaplain. When I talked to Dr Ward about his long career, we touched upon some sensitive topics: Does the presence of a Christian chaplain in the military mean God’s approval of military operations? How does a military chaplain serve in the context of a conflict?				            
            
        Misleading bridges, and better prayers
				                                    					Bridges seem to be the emblem of existential stress for Romanians. In the face of a difficult situation, even Romanian folk wisdom recommends: "Make a pact with the devil until you have crossed the bridge."				            
            
        How lethal is COVID-19, and other (un)answered questions
				                                    					There have now been over 12 million cases of COVID-19 infection globally, and half a million deaths. Researchers are constantly looking for new and better information to reduce the uncertainty around the virus.				            
            
        Jesus: Where two worlds meet
				                                    					Un hombre pasa con un pan al hombro.../Otro busca en el fango huesos, cáscaras/¿Cómo escribir después del infinito?				            
            
        Strong prayers to the hidden God
				                                    					No one has ever seen God, but the One who knew Him before He was born on this earth taught us all to address Him in prayer.				            
            
        The darker side of our world
				                                    					The world of the homeless is the darker side of our world. It is inhabited by vagrants, drug addicts, and the powerless. This world has its own rules, customs, pleasures, and pains, but lacks meaning and peace. And those who enter this world struggle to leave it.				            
            
        When faith falters, and couples drift apart
				                                    					Live the questions now. Perhaps you will then gradually, without noticing it, live along some distant day into the answer. – Rainer Maria Rilke				            
            
        Antibiotics: Blind optimism is dangerous
				                                    					The increased frequency with which doctors are encountering antibiotic-resistant bacteria is worrying. And it could affect an already precarious medical field—cancer treatment.